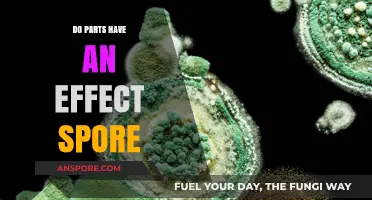
Do Parts Influence Spore Growth? Exploring the Impact of Components

Mushroom spores, the microscopic reproductive units of fungi, play a crucial role in the life cycle of mushrooms, but their germination and development are influenced by various environmental factors. One common question among enthusiasts and researchers is whether mushroom spores require light to grow. Unlike plants, which rely on light for photosynthesis, mushroom spores do not necessarily need light to germinate or develop into mycelium, the vegetative part of the fungus. However, light can still play a role in certain stages of mushroom growth, such as influencing the direction of fruiting body formation or triggering specific developmental processes in some species. Understanding the relationship between light and mushroom spores is essential for successful cultivation and for appreciating the complex biology of these fascinating organisms.
| Characteristics | Values |
|---|---|
| Light Requirement for Germination | Mushroom spores do not require light to germinate. |
| Light Requirement for Growth | Light is generally not necessary for mycelium growth but can influence fruiting body formation in some species. |
| Photoreceptors | Mushrooms lack chlorophyll but may have light-sensitive proteins like opsins. |
| Fruiting Body Development | Some mushroom species require specific light conditions (e.g., blue or red light) to initiate fruiting. |
| Light Intensity | Low to moderate light levels are sufficient for fruiting in light-sensitive species. |
| Light Duration | Consistent light exposure (e.g., 12 hours daily) may be needed for fruiting in some species. |
| Species Variability | Light requirements vary widely among mushroom species; some are indifferent, while others are highly sensitive. |
| Artificial Lighting | LED lights (blue or red spectrum) are often used in cultivation to simulate natural light conditions. |
| Natural Light | Indirect or diffused natural light is typically adequate for fruiting in light-sensitive species. |
| Darkness Tolerance | Many mushroom species can fruit in complete darkness, depending on the species. |
Explore related products
What You'll Learn
- Light's Role in Spore Germination: Does light trigger mushroom spore germination, or is darkness preferred
- Impact of Light Intensity: How does varying light intensity affect spore viability and growth
- Light Spectrum Effects: Do specific light wavelengths (e.g., blue, red) influence spore development
- Light vs. Mycelium Growth: Is light necessary for mycelium growth after spore germination
- Natural vs. Artificial Light: Do mushroom spores respond differently to natural sunlight versus artificial light

Light's Role in Spore Germination: Does light trigger mushroom spore germination, or is darkness preferred?
Mushroom spores, unlike seeds, do not inherently require light to germinate. This distinction is crucial for cultivators and mycologists alike. Spores are remarkably resilient, capable of lying dormant for years until conditions are favorable. However, while light is not a strict necessity, its role in spore germination is nuanced and depends on the species. Some mushrooms, like those in the *Coprinus* genus, exhibit positive phototropism, meaning light can stimulate germination. Others, such as certain *Agaricus* species, may germinate equally well in darkness. Understanding this variability is key to optimizing cultivation practices.
For those attempting to cultivate mushrooms, the question of light becomes practical. Spores typically require moisture, oxygen, and a suitable substrate to germinate. Light, when used, often serves as a signal rather than an energy source. For example, exposing spores to a brief period of indirect light (around 12–24 hours) can mimic natural conditions, encouraging germination in species that respond to light cues. However, prolonged exposure to direct light can be detrimental, as it may dry out the substrate or inhibit growth. A controlled environment with low-intensity, diffused light is ideal for species that benefit from illumination.
The preference for darkness in spore germination is more common than light sensitivity. Many mushroom species, such as *Psilocybe* and *Stropharia*, thrive in dark or dimly lit conditions. In nature, spores often germinate beneath leaf litter or soil, where light is minimal. For cultivators, this means that a dark incubation period—typically 7–14 days—is essential for these species. During this phase, maintaining high humidity (around 90–95%) and a stable temperature (22–26°C) is critical. Light should be introduced only after mycelium has colonized the substrate, as it can hinder early growth stages.
A comparative analysis reveals that light’s role in spore germination is species-specific and context-dependent. For instance, *Pleurotus ostreatus* (oyster mushrooms) show no significant difference in germination rates between light and dark conditions, whereas *Ganoderma lucidum* (reishi mushrooms) may benefit from a short light exposure. Cultivators should research their target species to determine the optimal approach. A general rule of thumb is to start with darkness for germination and introduce light only during later stages, such as fruiting body development, where it can influence shape and color.
In conclusion, while mushroom spores do not universally require light to germinate, its strategic use can enhance success for certain species. Darkness remains the preferred condition for most, particularly during the initial germination phase. By tailoring light exposure to the specific needs of the mushroom species, cultivators can maximize yields and ensure healthy growth. Whether leveraging light as a trigger or maintaining darkness, understanding this dynamic is essential for effective mushroom cultivation.
Could Spores Survive Reentry? Exploring Microbial Resilience in Space Travel
You may want to see also

Impact of Light Intensity: How does varying light intensity affect spore viability and growth?
Light intensity plays a pivotal role in the viability and growth of mushroom spores, acting as a catalyst for critical developmental processes. Spores, the microscopic seeds of fungi, are not merely passive entities; they respond dynamically to their environment, particularly to light. Research indicates that light intensity can influence the germination rate, mycelial growth, and even the formation of fruiting bodies. For instance, low to moderate light levels (around 500–1,000 lux) often stimulate spore germination, while higher intensities (above 2,000 lux) may inhibit growth or trigger premature fruiting. This sensitivity to light is rooted in the spores' photoreceptors, which detect and respond to specific wavelengths, primarily in the blue and red spectrum.
To optimize spore viability, cultivators must carefully calibrate light exposure. A practical approach involves starting with a low-intensity light source, such as a fluorescent or LED grow light, positioned 12–18 inches above the substrate. Gradually increasing light intensity over 7–10 days mimics natural conditions and encourages uniform germination. However, caution is necessary: excessive light, particularly in the UV range, can damage spores and reduce viability. For example, exposure to direct sunlight (approximately 100,000 lux) for more than 2 hours can degrade spore cell walls, rendering them non-viable. Thus, indirect or diffused light is preferable during the initial stages of cultivation.
Comparatively, the impact of light intensity varies across mushroom species. Photophilic species like *Psilocybe cubensis* thrive under higher light levels (1,500–2,000 lux), which promote robust mycelial growth and fruiting. In contrast, photophobic species such as *Stropharia rugosoannulata* prefer dimmer conditions (500–800 lux), where excessive light can suppress growth. This species-specific response underscores the importance of tailoring light intensity to the mushroom type. For instance, using a light meter to monitor and adjust intensity ensures optimal conditions for each species, maximizing yield and quality.
A persuasive argument for controlled light exposure lies in its ability to enhance spore longevity and productivity. Spores stored in complete darkness may remain viable for months, but their germination rates often decline over time. Introducing low-intensity light (300–500 lux) during storage can maintain dormancy while preserving viability. For cultivators, this translates to higher success rates in subsequent plantings. Additionally, light-induced stress can stimulate spore resilience, preparing them for environmental challenges like temperature fluctuations or nutrient scarcity. By strategically manipulating light intensity, growers can cultivate healthier, more resilient fungi.
In conclusion, varying light intensity is not merely a passive factor but an active determinant of spore viability and growth. From germination to fruiting, light acts as a signaling mechanism, guiding developmental processes. Practical steps, such as using grow lights, monitoring intensity, and species-specific adjustments, empower cultivators to harness this phenomenon effectively. Whether for hobbyists or commercial growers, understanding and controlling light intensity is essential for unlocking the full potential of mushroom spores.
Pollen vs. Spores: Understanding the Difference in Plant Reproduction
You may want to see also

Light Spectrum Effects: Do specific light wavelengths (e.g., blue, red) influence spore development?
Mushroom spores, unlike seeds, do not require light for germination. However, the influence of light on spore development becomes significant once they transition into mycelium, the vegetative part of the fungus. Specific wavelengths of light, particularly blue and red, play a pivotal role in this process. Blue light (400–500 nm) is known to stimulate mycelial growth and branching, while red light (600–700 nm) often triggers fruiting body formation. For cultivators, this means that exposing mycelium to a balanced spectrum of blue and red light can optimize growth and yield. For instance, using LED grow lights with a 1:1 ratio of blue to red wavelengths during the mycelial stage can enhance colonization speed, while increasing red light exposure during the fruiting stage encourages mushroom formation.
The dosage and duration of light exposure are critical factors. Studies suggest that mycelium benefits from 12–16 hours of daily light exposure, with blue wavelengths dominating the initial growth phase. During fruiting, red light should be increased to 80–90% of the spectrum, with exposure reduced to 8–12 hours daily to mimic natural day-night cycles. Over-exposure to red light during the mycelial stage can prematurely induce fruiting, stunting overall growth. Conversely, insufficient red light during fruiting may delay or inhibit mushroom development. Practical tip: Use a light meter to ensure the intensity remains between 500–1,000 lux, as higher intensities can stress the mycelium.
Comparing natural light to artificial sources reveals interesting nuances. Sunlight provides a full spectrum, including UV rays, which can inhibit certain mushroom species but benefit others like *Psilocybe* spp. Artificial LED lights, however, allow precise control over wavelengths, making them ideal for indoor cultivation. For example, *Oyster mushrooms* (*Pleurotus ostreatus*) respond well to a blue-heavy spectrum during mycelial growth, while *Shiitake* (*Lentinula edodes*) thrives under a red-dominant spectrum during fruiting. Caution: Avoid green and yellow wavelengths, as they have minimal impact on fungal development and can waste energy.
Persuasively, the use of tailored light spectra is not just a luxury but a necessity for maximizing mushroom yields. Commercial growers often invest in programmable LED systems that adjust wavelengths and intensities automatically, ensuring optimal conditions at each growth stage. For hobbyists, affordable DIY setups using blue and red LED strips can yield significant improvements over natural light alone. Example: A study on *Lion’s Mane* (*Hericium erinaceus*) showed a 30% increase in fruiting body weight when exposed to a red-heavy spectrum compared to white light. This underscores the importance of understanding and applying light spectrum effects in mushroom cultivation.
Descriptively, the interaction between light and fungi is a dance of biology and physics. Blue light penetrates deeper into the mycelium, promoting cellular division and energy production via photosynthesis-like pathways. Red light, on the other hand, acts as a signal for reproductive processes, akin to its role in flowering plants. This duality highlights the evolutionary adaptability of fungi, which have co-opted light cues to thrive in diverse environments. By mimicking these natural signals, cultivators can unlock the full potential of mushroom species, turning light spectrum manipulation into a powerful tool for both science and agriculture.
Sanding Stained Wood: Can You Smooth Spots After Staining?
You may want to see also
Explore related products

Light vs. Mycelium Growth: Is light necessary for mycelium growth after spore germination?
Mushroom spores, once germinated, initiate the growth of mycelium—the vegetative part of the fungus that forms a network of thread-like structures. A common question among cultivators and enthusiasts is whether light plays a critical role in this stage. While light is essential for spore germination, its necessity for mycelium growth is less straightforward. Mycelium thrives in dark, nutrient-rich environments, often beneath the soil or within substrates like wood or compost. This raises the question: does light hinder or promote mycelium development after germination?
From an analytical perspective, mycelium growth is primarily driven by factors like humidity, temperature, and nutrient availability rather than light exposure. Studies show that mycelium can grow robustly in complete darkness, provided other conditions are optimal. Light, in fact, can sometimes inhibit growth by causing the mycelium to allocate energy toward fruiting body formation prematurely. For instance, exposure to light during the mycelium stage may trigger the fungus to redirect resources toward producing mushrooms, potentially stunting the mycelial network’s expansion.
Instructively, cultivators aiming to maximize mycelium growth should prioritize darkness during this phase. Keep substrates in opaque containers or dark rooms, maintaining a temperature range of 70–75°F (21–24°C) and humidity levels around 60–70%. Avoid direct light exposure, especially from UV sources, which can damage the mycelium. If using a grow tent, ensure it’s light-tight during the mycelium colonization period, typically lasting 7–14 days depending on the species and substrate.
Comparatively, while light is crucial for photosynthesis in plants, fungi lack chlorophyll and do not rely on light for energy production. Instead, they obtain nutrients by breaking down organic matter. This fundamental difference highlights why light’s role in mycelium growth is minimal. However, some species, like *Photomyces*, exhibit phototropism, growing toward light sources. These exceptions underscore the diversity of fungal responses to light but do not negate the general rule that darkness is optimal for mycelium development.
Practically, if you’re cultivating mushrooms, focus on creating a dark, stable environment for mycelium growth. Use a hygrometer to monitor humidity and a thermometer to maintain temperature consistency. Avoid peeking excessively into the growing area, as even brief light exposure can disrupt the process. Once mycelium fully colonizes the substrate, introduce controlled light to initiate fruiting body formation. This phased approach ensures healthy mycelium development before transitioning to the fruiting stage, maximizing yield and quality.
Do Mold Spores Dry Out? Understanding Their Survival and Persistence
You may want to see also

Natural vs. Artificial Light: Do mushroom spores respond differently to natural sunlight versus artificial light?
Mushroom spores, the microscopic seeds of fungi, are remarkably resilient yet selective in their germination requirements. Light, whether natural or artificial, plays a pivotal role in signaling to spores that conditions are favorable for growth. Natural sunlight, a full-spectrum light source, contains ultraviolet (UV) rays and infrared radiation, which can both inhibit and stimulate spore germination depending on intensity and duration. Artificial light, on the other hand, often lacks these components, offering a narrower spectrum that may or may not meet the spores' needs. This distinction raises the question: do mushroom spores respond differently to natural sunlight versus artificial light?
To explore this, consider the germination process of * Psilocybe cubensis*, a commonly studied mushroom species. Spores of this fungus require a specific light trigger to break dormancy. Natural sunlight, with its broad spectrum, provides a consistent and reliable signal, often leading to higher germination rates. For instance, exposing *P. cubensis* spores to 12 hours of direct sunlight daily can increase germination by up to 30% compared to complete darkness. However, prolonged exposure to UV rays can also damage spores, making timing and intensity critical. Artificial light, such as fluorescent or LED grow lights, can mimic sunlight but often lacks UV rays. While this reduces the risk of damage, it may also limit the spores' ability to detect the light signal effectively.
From a practical standpoint, cultivators must balance these factors when choosing a light source. For indoor mushroom cultivation, artificial light is often the only option. Using full-spectrum LED lights with a color temperature of 6500K can simulate daylight effectively, promoting spore germination without the risk of UV damage. However, these lights should be placed 6–12 inches above the substrate and operated on a 12-hour cycle to mimic natural day-night patterns. For outdoor cultivation, shading spores during peak sunlight hours (10 AM–4 PM) can prevent UV overexposure while still allowing them to receive the necessary light cues.
A comparative analysis reveals that while natural sunlight is optimal for spore germination, it is not always practical or controllable. Artificial light offers consistency and safety but requires careful calibration to replicate sunlight's benefits. For example, *Oyster mushroom* spores (*Pleurotus ostreatus*) show a 20% higher germination rate under natural sunlight compared to artificial light, but the latter allows for year-round cultivation in controlled environments. This trade-off highlights the importance of understanding the specific needs of each mushroom species and tailoring light exposure accordingly.
In conclusion, mushroom spores do respond differently to natural sunlight and artificial light, with each offering unique advantages and challenges. Natural sunlight provides a full spectrum of light that enhances germination but carries the risk of UV damage. Artificial light, while safer and more controllable, may lack the necessary components to fully stimulate spores. Cultivators must weigh these factors, considering species-specific requirements, environmental conditions, and cultivation goals. By mastering the interplay between natural and artificial light, growers can optimize spore germination and ultimately achieve successful mushroom cultivation.
How to Play Spore on LAN: A Step-by-Step Multiplayer Guide
You may want to see also
Frequently asked questions
Mushroom spores do not require light to germinate. They can sprout in darkness, but light can influence the growth and development of the mycelium after germination.
While light is not necessary for spore germination, it can impact the direction and rate of mycelium growth. Some mushroom species may respond to light by growing toward or away from it.
Yes, mushroom spores can grow in complete darkness. However, the absence of light may affect the fruiting body formation and overall development of the mushroom.
Light is not essential for spore viability. Spores can remain viable in the dark for extended periods, but light exposure during later growth stages may be beneficial for some species.